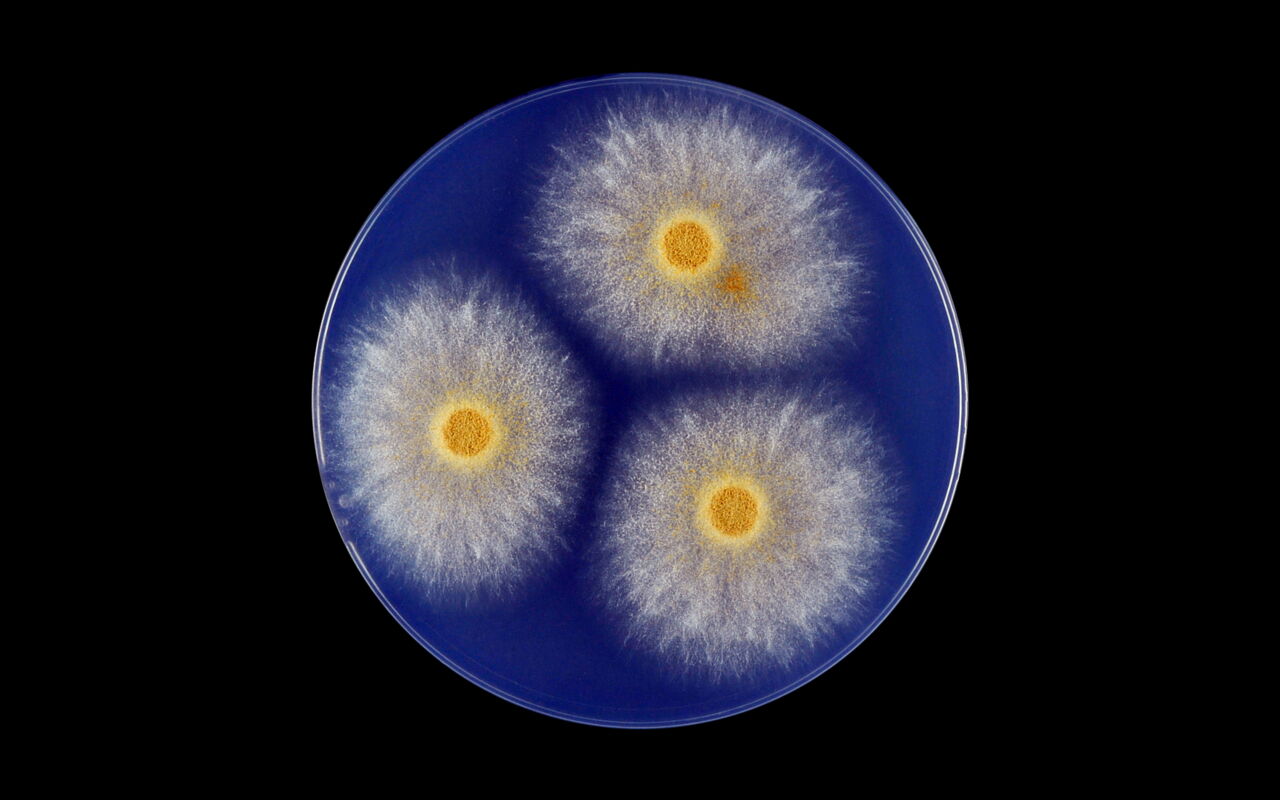

|
W
Meteo
Caroline Receveur atteinte d’un cancer : cette bouleversante réaction de son fils Marlon, 5 ans / Caroline Receveur atteinte d'un cancer : le magnifique geste de son fils Marlon / Champignons responsables de maladies humaines : comment les surveille-t-on ?
Subscribe to:
Post Comments (Atom)
...
تورس
like fb
....
تونس اليوم
عاجل
EN CONTINU
يهمكم
علوم و تكنولوجيا
أخبار كرة القدم
👍 ❤️❤️❤️❤️
-
حبيبي ليس يعدله حبيب *** ولا لسواه في قلبي نصيب حبيب غاب عن بصري وسمعي *** ولكن في فؤادي ما يغيب يا حبيب ...
-
أيمن الدبوسي أعمل في مستشفى الرازي، وهذا أمر سيئ للغاية. هنا لا يوجد مجانين. إنّهم آخر شيء تتوقع العثور عليه في هذا المكان. شخصيّاً، لم أق...

No comments:
Post a Comment
🤔